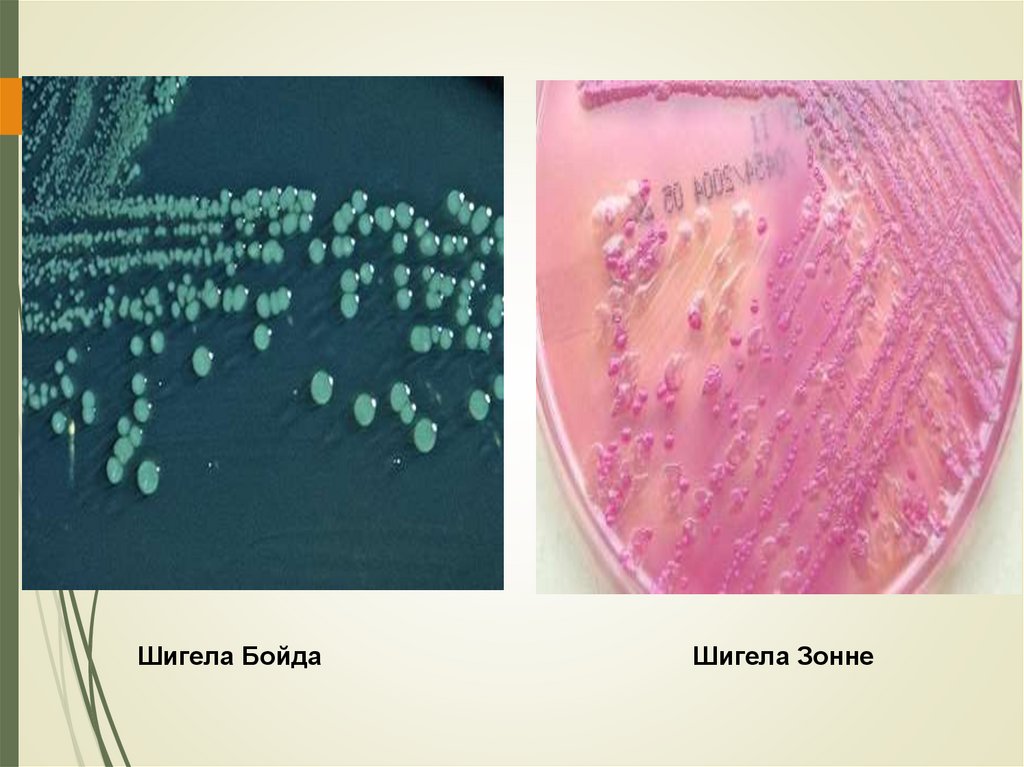
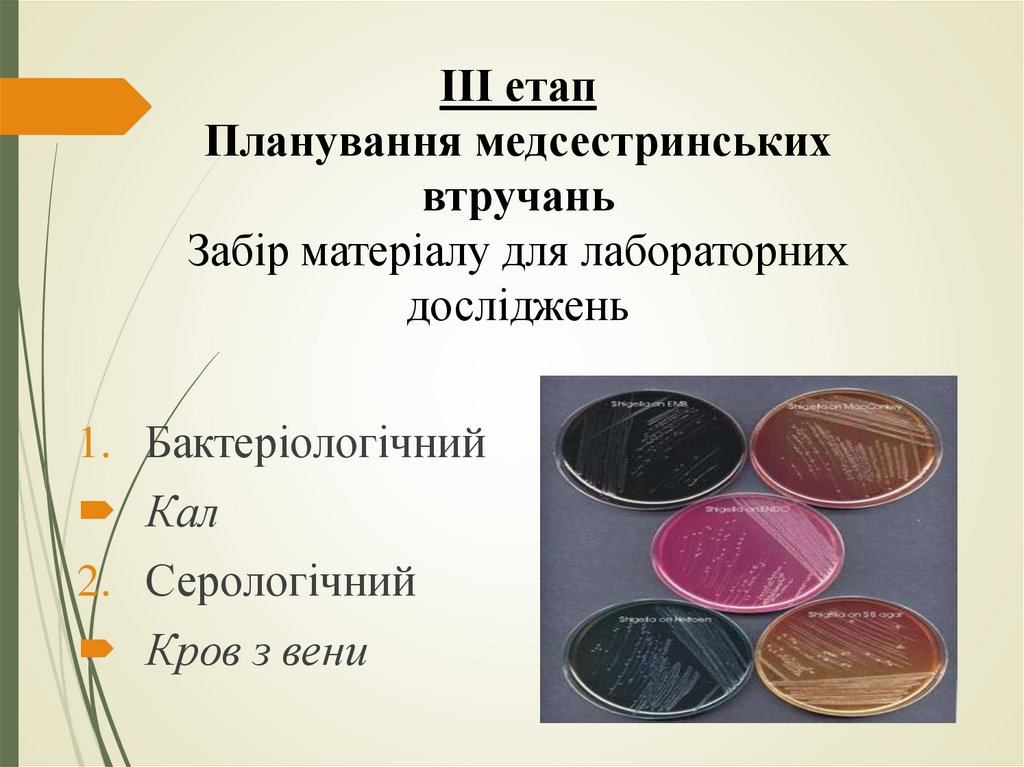

Similar presentations:
Шигельоз. Холера. Лекція 5
1.
Лекція 5Шигельоз. Холера
2.
Шигельоз- гостра бактеріальна антропонознаінфекційна хвороба з фекально- оральним
механізмом передачі,що характеризується
ураженням дистального відділу товстої кишки,
частими випорожненнями з домішками слизу та
кров в калі, болем в животі, підвищенням
температури тіла та симптомами загальної
інтоксикації.
3. Етіологія
1) Sh. dysenteriae (Григор'єва-Шига, Штуцера-Шмітца,Ларджа-Сакса);
2) Sh. flexneri;
3) Sh. boydii;
4) Sh. sonnei
Продукують ендотоксин, Григор'єва-Шига - екзотоксин
4.
5.
Шигела БойдаШигела Зонне
6. Етіологія
Зберігаються:В грунті
Воді
На харчових продуктах
В молоці
Чутливі до:
Високих температур
Прямого сонячного світла
Дезрозчинів
7. Епідеміологія
Джерело інфекції: хвора людина,бактеріоносій
Механізм передачі: фекальнооральний
Шляхи передачі;
Харчовий: молоко, немиті овочі та
фрукти
Водний: питна вода, під час купання
Контактно-побутовий: посуд, немиті
руки, рушник
8.
9.
Сезонність – літньо-осінняСприятливість: частіше
хворіють діти
Імунітет – короткочасний до 1
року
10. Класифікація
I. Гострий шигельоз:1. Колітна форма:
- легка
- середньої важкості
- важка
2. Гастроентероколітна
II. Хронічний шигельоз
- безперервна
- рецидивуюча
III. Бактеріоносійство
11.
12. Медсестринський процес І етап – медсестринське обстеження CКАРГИ
підвищення температури тілаголовний біль
переймоподібні болі в нижній частині живота, переважно
в лівій здухвинній області;
зменшення або короткочасне зникнення після дефекації
позиви до дефекації з'являються одночасно з болем або
дещо пізніше.
дефекація може супроводжуватися тенезмами,
виникають псевдопозиви;
13. Анамнестичні дані
Інкубаційний період 1-7 дібГострий початок
Синдром інтоксикації (головний біль, озноб, загальне
нездужання)
Синдром ураження товстої кишки (переймоподібний біль
у лівій здухвинній ділянці, пронос, несправжні поклики,
тенезми)
14. Об’єктивно
Шкірні покриви блідіЯзик обкладений нальотом
Гарячка 37,2-38 С ( при важкому перебігу
висока)
Сигмоподібна кишка при пальпації
набрякла, спазмована, болюча
випорожнення спочатку калові →
з'являється домішки слизу і крові;
частота дефекацій наростає;
Чим частіші випорожнення тим менший їх
об’єм
Випорожнення мізерні, слизисті з
прожилками крові (при важкому перебігу з
гноєм) –
Випорожнення у вигляді ректального
плювка
15.
16. УСКЛАДНЕННЯ
інфекційно-токсичний шок (у разі Григорьєва-Шига)дисбактеріоз
перфорація кишечника
парези і інвагінації кишечника
тріщини та ерозії прямої кишки, геморой,
випадіння слизової оболонки прямої кишки
дисфункції кишечника (післядизентерійній коліт)
17. ІІІ етап Планування медсестринських втручань Забір матеріалу для лабораторних досліджень
1. БактеріологічнийКал
2. Серологічний
Кров з вени
18. IV етап Реалізація плану медсестринських втручань Вирішення проблем та потреб пацієнта
Виділити пацієнту окреме судноПідтримувати в палаті температуру +23-24 С, при
вираженому ознобі зігріти хворого
Контроль за дотриманням ліжкового режиму
Контроль в дотриманні дієти
Контроль за чистотою натільної та постільної білизни
Контроль за чистотою шкірних покривів
Вимірювання тиску, пульсу, температури пацієнта
Контроль за частотою та вмістом стільця
Проведення поточної дезінфекції
19. Виконання лікарських призначень
Ліжковий режимДієта
Антибактеріальна терапія: фторхінолони, тетрацикліни,
ампіциллін, цефалоспорин, а також комбіновані
сульфаніламіди
Еубіотики: біфідумбактерин, біфікол, колібактерин,
лактобактерин
Дезінтоксикаційна терапія (в/в ізотонічні розчини)
Ферментні препарати (панзинорм, мезим-форте)
Ентеросорбенти (смекта, энтеросорб,)
Спазмолітики: папаверин, ношпа
Лікувальні мікроклізми з настоями эвкаліпта, ромашки,
масел шипшини і обліпихи.
20.
V етапОцінка результатів медсестринських
втручань та їх корекція
Нормалізація випорожнень
Покращення апетиту, нормалізація загального
стану
Відсутність болю в животі та тенезмів
Зниження температури тіла
21. Профілактика
Ізоляція пацієнтів (вдома, стаціонар)Виписка пацієнтів після 2-разового контрольного
бактеріологічного дослідження
Диспансерний нагляд за перехворілими 3 міс в КІЗі
Недопущення носіїв до роботи в харчовій промисловості
та водопостачанні
Бактеріологічний контроль декретованих (працівники
харчової промисловості) 1 раз на 6 міс
Вогнищева та профілактична дезінфекція
22. Профілактика
Миття рукІндивудуальний посуд
Кип’ятіння питної води
Миття харчових продуктів (овочі, фрукти)
Боротьба з мухами
Раннє формування у дітей гігієнічних навичок
23.
Холера – гостра антропонозна особливо небезпечнахвороба, що спричиняється холерними вібріонами, має
фекально-оральний механізм зараження, характеризується
епідемічним поширенням, бурхливим перебігом з
вираженою діареєю, яка супроводжується втратою рідини
(зневодненням), електролітів (знесолення), ацидозом.
24. Етіологія
морфологіязбудника
біовари Vibrio cholerae; Vibrio
cholerae asiaticea та Vibrio El-Tor
Має форму палички-коми
монотрих , грамнегативний
Виділяє екзотоксин - холероген
фізіологія
Добре росте на лужних
середовищах
Стійкий до низьких температур
25. Холерні вібріони
26. Етіологія
Збереженнязбудника в
довкіллі
грунт
вода
стічні води
морська вода
на харчових
продуктах
27. Етіологія
кислотвисоких температур
збудник
чутливий
до:
висушування
прямого сонячного світла
дезрозчинів
28. Епідеміологія
Джерело інфекціїхвора людина
реконвалесцент
здоровий
вібріоносій
29.
Механізм зараження- фекально-оральнийШляхи предачі:
Водний
Харчовий
Контактнопобутовий
• Інфікована питна вода
• Купання у водоймах
• Рибні продукти
• Фрукти,овочі
• М’ясо
• Молоко
• Брудні руки
• Погані санітарногігієнічні умови
• Мухи,таргани
30.
31.
КласифікаціяЗа тяжкістю перебігу
по ступені зневоднення
За формою
I - втрата рідини
1-3% маси тіла
легкий пребіг
вібріононосійство
II - втрата рідини
4-6% маси тіла
середньої
важкості
стерта форма
III - втрата рідини
7-9% маси тіла
тяжкий
перебіг
блискавична, суха
IV - втрата рідини
10% і більше маси тіла
дуже
тяжкий
геморагічна
32.
Класифікація ВООЗ:1) 1) І ст- втрата рідини 1-5% маси тіла
2) ІІ ст- втрата рідини 5-9% маси тіла
3) ІІІ ст- втрата рідини 10% і більше маси тіла
33. І етап – медсестринське обстеження
Скарги пацієнта:Неприємні відчуття в
пупковій ділянці
Спрага
Пронос
Сухість в роті
Блювання раптове
Похолодання кінцівок
Загальна слабість
Запаморочення
Біль у жувальних і
литкових м’язах
34.
Анамнестичні даніІнкубаційний період від 6 годин до 6 днів
Початок хвороби гострий: раптовий позив
до дефекації
Профузний пронос, спочатку випорожнення
кашкоподібні, а потім - водянисті без запаху
Позиви до дефекації повторюються, без болючих відчуттів,
випорожнення виділяються легко
35. Об’єктивно
Температура тіла субнормальна (36,6-35,5) або зниженаПульс ниткоподібний, тахікардія АТ – знижений (гіпотензія)
Адинамія, байдужість
Пронос у вигляді відвару (рисового) відвару
Блювання (посилюється при спробі пити)
Живіт втягнутий, неболючий при пальпації
Язик сухий з білим налетом
Шкірні покриви бліді, ціанотичні, зниження еластичності
шкіри
Судоми різних груп м’язів
Задишка , осиплість голосу, афонія
Олігурія, анурія
36.
37.
38.
39.
40.
«Руки пралі»41. ІІ етап Медсестринська діагностика
МЕДСЕСТРИНСЬКІ ДІАГНОЗИДіарея
Профузне блювання
Дегідратація (зневоднення)
Зниження температури тіла, похолодання тіла і кінцівок
Спрага
Судоми
Запаморочення
42. ІІІ етап Планування медсестринських втручань
Підготовка пацієнта та взяття інфікованого матеріалу дляспецифічних лабораторних досліджень
Вирішення проблем і потреб пацієнта
Виконання лікарських призначень
Дотриманння заходів безпеки для запобігання
поширенню карантинної інфекції
Вирішення супутніх проблем пацієнта
43. IV етап Реалізація плану медсестринських втручань
1.2.
3.
4.
5.
6.
Взяття калу на копрокультуру
Взяття блювотних мас для бактеріологічного
дослідження
Взяття жовчі у реконвалесцентів для бактеріологічного
дослідження
Забір інфікованих продуктів, змивів з об’єктів
навколишнього середовища для бактеріологічного
дослідження
Забір крові з вени для серологічного та біохімічного
досліджень
Дотримання суворого протиепідемічного режиму – при
заборі і доставці матеріалу в лабораторію
44.
45. Вирішення проблем пацієнта Створенння комфортних умов Контроль за дотриманням режиму
1.2.
3.
4.
5.
6.
7.
8.
Постійний контроль за самопочуттям і станом пацієнта
(вимірювання АТ, Т, Р)
Точний облік втрат рідини
Надання допомоги при блюванні
Надання допомоги при проносах
Контроль за дотриманням чистоти: шкіри, слизових,
білизни
Застосування тепла при гіпотермії (грілки, висока Т в
палаті)
Контроль та допомога в дотриманні дієти (вживати
продукти багаті калієм: курага, банани...)
Контроль за проведенням поточної дезінфекції
46. Виконання лікарських призначень
1.Підготувати пацієнта, систему для в/в введення
регідратаційних розчинів (голки з великим просвітом)
2.
Підготувати відповідні розчини , підігріти їх до +38-400 С)
3.
В/в ведення регідратаційних розчинів
4.
Реєстрація складу і кількості введення лікувальних розчинів
5.
Пероральна регідратація (ораліт, дисіль)
6.
Здійснення парентеральної регідратації (II-IV ступені)
“Квартасіль”, “Трисіль”, “Ацесіль”, “Хлосіль”, “Лактосіль”
7.
При відсутності блювання, або після його припинення –
роздача ліків для перорального прийому:
тетрациклін
Фуразолідон, морфоциклін, еритроміцин та ін.
47. Транспортування хворого
48.
49.
50. V етап Оцінка результатів медсестринськив втручань та їх корекція
Покращення загального стану та самопочуття пацієнта(зникнення спраги, судомів, відновлення апетиту, сну,
нормалізація кольору шкіри)
Нормалізація температури тіла, пульсу, АТ
Нормалізація стільця, припинення блювання
Виявлення та оцінка нових проблем пацієнта (можливих
ускладнень – пневмонія, флегмона, абсцес, цистит та ін) з
відповідною корекцією м/с втручань
51. Профілактика заходи відносно джерела
1.2.
Раннє виявлення хворих і вібріоносіїв, їх ізоляція
Дотримання правил виписки (триразове бакдослідження
калу, а у декретованих осіб ще й одноразово жовч)
3.
Бактеріологічний контроль за особами, які працюють в
дитячих лікувальних закладах, у сфері громадського
харчування, а також комунального господарства
52. Протиепідемічні заходи в осередку холери
Виявлення хворих, їх ізлоляція в холерні відділенняВиявлення та ізоляція (карантин) контактних на 5 днів
та бактеріолоогічне їх обстеження
Контактним екстренна профілатика (тетрациклінові
антибіотики, бактеріофаг)
Поточна і заключна дезінфекція
У вогнищі інфекції обмежувальні заходи
Обов’язкові щоденні подвірні обходи з ретельним
збором епідемічного анамнезу
53.
54. Загальносанітарні заходи
• Контроль за водопостачанням, каналізацією, ринками,громадським харчуванням
• Боротьба з мухами
• Дотримання правил особистої та харчової гігієни:
• Правильне користування водоймами
• Вживання кип’яченої води
• Термічна обробка їжі
• Часте миття рук
• Санітарно-освітня робота
55. Специфічні заходи профілактики
• При несприятливій епідемічній ситуації – вакцинаціяентеральною хімічною вакциною та холероген́́́́́́́́́́
анатоксином
́́́́́́́́́́́́́́́́́́́́ ́́́́́́́́́́ ́́́́́́́́́́ ́́́́́́́́́́
́́́́́́́́́́
́́́́́́́́́́
́́́́́́́́́́
• О́́́́́́́́́́бов’язкова санітарна охорона кордонів від завезення
інфекції ззовні
• За особами, що прибули з неблагополучних щодо холери
регіонів – спостереження протягом 5 днів, одноразове
бактеріологічне дослідження калу

medicine
medicine








